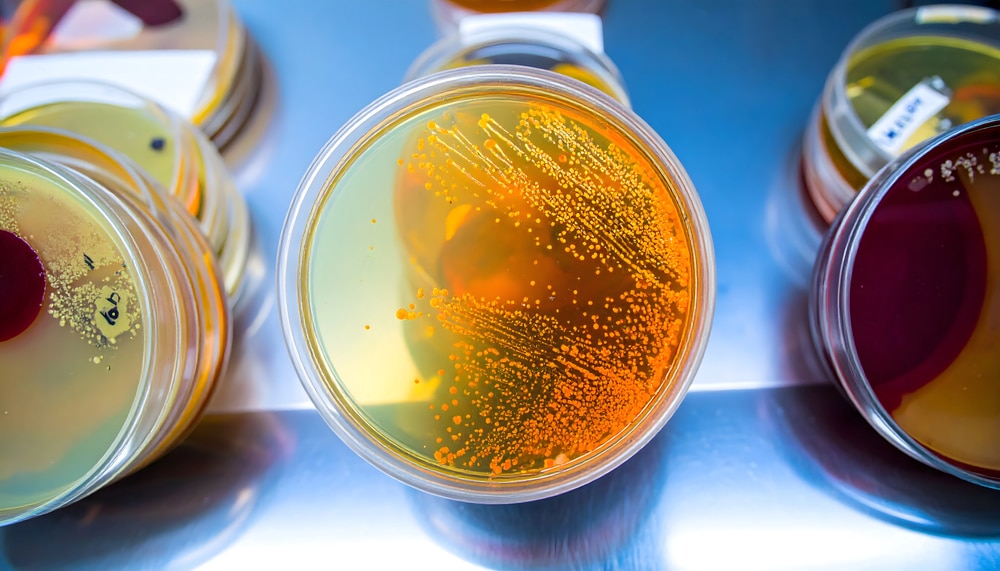
Microbiologia

Calibração De Equipamentos De Microbiologia E Sua Relevância Na Segurança Dos Alimentos
A segurança alimentar é um pilar essencial para garantir a saúde pública. No contexto da microbiologia dos alimentos, busca-se identificar e controlar microrganismos que possam comprometer a qualidade dos produtos alimentícios.
Detectar e prevenir a presença de patógenos é crucial para evitar doenças e a deterioração dos alimentos. A microbiologia atua como uma ferramenta vital na proteção dos consumidores, assegurando que os alimentos sejam seguros para o consumo.
Métodos de Detecção Microbiológica
Na microbiologia dos alimentos, diferentes métodos são aplicados para assegurar que nenhum patógeno passe despercebido. Um dos métodos mais comuns é o teste de contagem de colônias. Ele quantifica o número de microrganismos presentes em uma amostra, como em laticínios, onde se determina a qualidade microbiológica pela contagem de colônias em placas.
A identificação de patógenos é outro método crucial. Essa técnica busca detectar microrganismos específicos que possam causar doenças, como a presença de Salmonella em carnes. A identificação precisa desses patógenos é vital para evitar surtos de doenças transmitidas por alimentos.
Além disso, a avaliação de condições de armazenamento é essencial para manter a qualidade dos alimentos. Por exemplo, monitorar a temperatura dos refrigeradores em supermercados garante que os produtos permaneçam em condições ideais, prevenindo a proliferação de bactérias indesejadas.
Esses métodos, quando bem aplicados e calibrados, são fundamentais para garantir a segurança e a qualidade dos alimentos que chegam à mesa do consumidor.
Importância da Calibração de Equipamentos
A calibração dos equipamentos em microbiologia é um pilar essencial para a garantia de resultados precisos. Sem ela, o risco de obter dados inconsistentes aumenta significativamente, comprometendo a capacidade de detectar microrganismos nocivos. Quando instrumentos como biorreatores e incubadoras funcionam fora dos parâmetros ideais, os resultados podem ser enganadores, levando a diagnósticos incorretos.
Além disso, a calibração inadequada impacta diretamente a cadeia de segurança alimentar. Se um equipamento não está devidamente calibrado, ele pode não apenas falhar na detecção de patógenos, mas também comprometer a qualidade do alimento processado. Isso pode resultar em produtos inseguros chegando ao consumidor final, aumentando o risco de doenças transmitidas por alimentos.
Consequentemente, a ausência de calibração rigorosa pode levar a problemas graves, como recalls de produtos e danos à reputação das empresas. Portanto, manter os equipamentos devidamente calibrados não é apenas uma questão técnica, mas um compromisso com a saúde pública e a confiança do consumidor.
Análise de Certificado de Calibração
O certificado de calibração é um documento essencial que atesta que um equipamento foi calibrado conforme padrões reconhecidos. Ele contém informações detalhadas sobre a precisão e o desempenho do equipamento, garantindo que os resultados sejam confiáveis e precisos.
Na microbiologia de alimentos, a validação de biorreatores e incubadoras é crucial. Esses aparelhos devem operar dentro de limites rigorosos para assegurar que as condições de crescimento de microrganismos estejam corretas. Um certificado de calibração ajuda a validar que esses equipamentos estão ajustados adequadamente, minimizando riscos de erros nas análises.
Um exemplo prático seria a análise de um certificado de calibração para uma incubadora. O documento deve especificar a temperatura de operação e os desvios permitidos. Comparando esses dados com os padrões metrológicos, é possível confirmar se a incubadora está apta ao uso.
Além disso, a rastreabilidade metrológica é fundamental. Ela assegura que cada etapa da calibração possa ser verificada e comprovada. Isso facilita auditorias internas e externas, garantindo que todos os processos sigam normas internacionais e aumentem a credibilidade dos resultados microbiológicos. Para aprofundar seus conhecimentos, considere o curso online sobre análise de certificados de calibração, que aborda esses conceitos de forma detalhada.
Confiabilidade dos Dados Microbiológicos
Em qualquer análise microbiológica, a confiabilidade dos dados é um elemento crucial para garantir a segurança alimentar. Dados precisos e padronizados são fundamentais para determinar a presença de microrganismos que podem comprometer a saúde humana. Isso se torna ainda mais relevante quando consideramos que até 60% dos erros em análises microbiológicas podem ser atribuídos a equipamentos mal calibrados.
A padronização dos resultados é vital pois assegura que as medições sejam consistentes e comparáveis ao longo do tempo. Sem essa padronização, há um risco significativo de variações nos resultados que podem levar a conclusões equivocadas, impactando a segurança dos alimentos de forma negativa.
A credibilidade dos laudos microbiológicos depende diretamente da calibração de equipamentos. Laudos confiáveis garantem que os padrões de segurança alimentar sejam cumpridos, ganhando a confiança de consumidores e reguladores. Além disso, uma calibração adequada reduz o risco de recalls e protege a reputação das empresas no mercado.
Portanto, investir na calibração regular dos equipamentos é essencial para manter a integridade dos dados microbiológicos e, consequentemente, a segurança alimentar.
Curso Online Análise e Validação de Certificados
Para profissionais que atuam em laboratórios de microbiologia de alimentos, compreender os princípios básicos de metrologia e a importância do escopo e rastreabilidade dos certificados é essencial. O curso online “Análise e Validação de Certificados de Calibração” da Cirius Quality foi desenvolvido para atender a essa necessidade.
O curso oferece uma base sólida sobre os conceitos fundamentais de metrologia, abordando como avaliar o escopo dos certificados e garantir a rastreabilidade metrológica. Isso ajuda a assegurar que todos os equipamentos utilizados em análises microbiológicas estejam devidamente calibrados e operem dentro dos padrões estabelecidos.
| Tópicos do Curso |
|---|
| Princípios Básicos de Metrologia |
| Escopo dos Certificados |
| Rastreabilidade Metrológica |
Ao final do curso, os participantes estarão melhor preparados para validar certificados de calibração, garantindo a precisão e confiabilidade dos dados microbiológicos e, por consequência, a segurança dos alimentos.
Benefícios do Curso para Profissionais
Para os profissionais da microbiologia de alimentos, participar do curso “Análise e Validação de Certificados de Calibração” oferece diversos benefícios essenciais. Um dos principais é a garantia de que todos os equipamentos estão devidamente calibrados. Isso é crucial para assegurar que os resultados das análises sejam precisos e confiáveis.
Além disso, o curso capacita os participantes a garantir a conformidade com as normas regulamentadoras vigentes. Isso não apenas evita problemas em auditorias, mas também fortalece a reputação do laboratório em termos de qualidade e segurança.
- Aprimoramento das habilidades em metrologia
- Capacidade de avaliar e validar certificados de calibração
- Conformidade com padrões de qualidade
Um aluno satisfeito relatou: “Após concluir o curso, me sinto muito mais confiante em conduzir calibrações e garantir que nosso laboratório atenda a todos os requisitos normativos. Isso trouxe mais segurança e eficiência para nossa equipe.”
Com esses benefícios, o curso se torna uma ferramenta valiosa para qualquer profissional que deseja alcançar excelência na segurança alimentar.
Boas Práticas de Documentação
Manter a documentação atualizada é uma prática essencial em qualquer laboratório de microbiologia. Documentos precisos e atualizados garantem a confiabilidade dos processos e a integridade dos resultados obtidos. Um exemplo de documentação correta é o registro detalhado de cada calibração realizada, incluindo data, hora, resultados e assinatura do responsável técnico.
Para facilitar auditorias internas e externas, é fundamental que todos os registros estejam organizados e facilmente acessíveis. Isso não só agiliza o processo de auditoria, como também demonstra o compromisso do laboratório com a qualidade e a conformidade regulatória. Utilizar sistemas de gestão documental pode ser uma excelente solução para garantir que todos os documentos estejam sempre em ordem.
Além disso, é importante que a equipe seja treinada para entender a importância da documentação e como mantê-la atualizada. Isso inclui não só a coleta de dados, mas também a revisão periódica dos documentos existentes para garantir que reflitam as práticas atuais do laboratório. Com essas práticas, um laboratório poderá melhorar significativamente sua eficiência e credibilidade.
Conclusão
A calibração de equipamentos de microbiologia é vital para garantir a precisão dos resultados, impactando diretamente a segurança alimentar. Sem calibração adequada, o risco de falhas na detecção de patógenos aumenta, comprometendo a saúde pública.
Portanto, é essencial que profissionais da área se capacitem continuamente. Considere participar do curso online “Análise e Validação de Certificados de Calibração” para aprofundar seus conhecimentos e assegurar a integridade dos processos laboratoriais.








0 comments
Write a comment